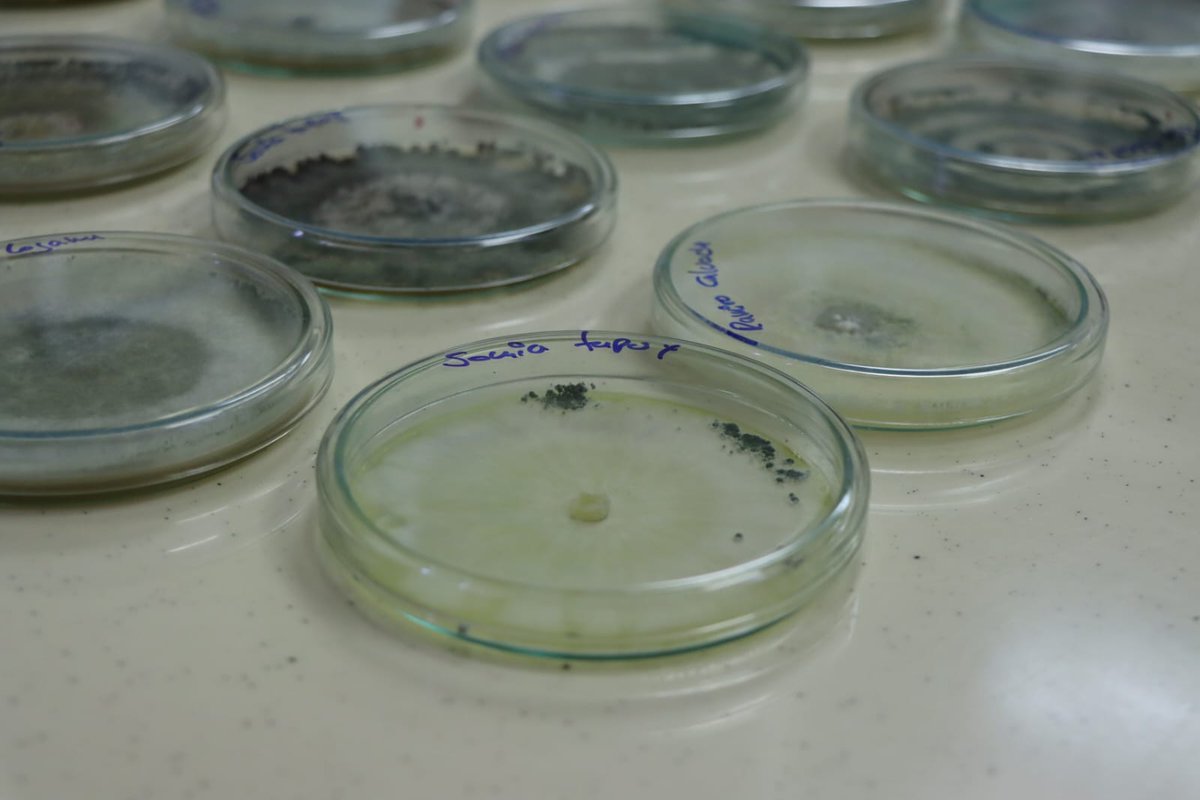
AgriculturaEc's tweet image. #Orellana | La investigación es el principal motor de cambio para el agro. En #JoyaDeLosSachas, el ministro @EizaguirreEc, visitó la Estación Experimental Central de la Amazonía de @INIAPECUADOR, donde evidenció el trabajo que realiza este instituto en varios cultivos de la zona.

Cris
@fuke_A
Ingeniera agrónoma amante a los animales🐶 a RHCP y Coldplay. ||||Siempre me faltara un tornillo y me sobrara una sonrisa ||||
You might like
El anti Correísmo surgió cuando las hijas y los hijos de las empleadas domésticas del Ecuador comenzaron a obtener mejores notas que los hijos de los patrones y se fueron a estudiar gratuitamente en las mejores universidades del mundo.

Mantuvimos una reunión con el Ministro de agricultura @DPalaciosEc, donde presentamos nuestro trabajo en investigación, transferencia de tecnología, innovación, productos y servicios. Nuestro fin es alinear los recursos para impulsar la tecnificación e innovación en el agro.


#Pichincha | Junto a Agripac y Ecuaquímica, llevamos a cabo dos días de capacitaciones en la Estación Exp. Santa Catalina para fortalecer las capacidades en el manejo de campos de multiplicación, fisiología, normativa actual y almacenamiento en la producción de semillas.




#FiasaEsAgro | En la Estación Experimental Litoral Sur contamos con laboratorio de suelos, tejidos vegetales y aguas. Instalaciones acreditadas y equipadas con tecnología de punta. Seguimos comprometidos con la mejora continua y la norma NTE ISO/IEC 17025.




#Chimborazo | Compartimos un día de campo en Calpi junto a productores de quinua, quienes recorrieron parcelas de la reciente variedad liberada de Quinua INIAP-EXCELENCIA. Los participantes fueron parte de una capacitación con el fin de aplicar este conocimiento es sus parcelas.




¡Hoy dimos el primer paso hacia la transformación del campo! Mediante los CDPAC las familias rurales podrán acopiar sus productos para vender directamente a mercados diferenciados; pero también recibirán en sus zonas los servicios que merecen del Estado. #NuestroTrabajoContinúa🇪🇨
"Nadie puede construir un mundo mejor sin mejorar a las personas". Marie Curie #Fuedicho

#Orellana | La investigación es el principal motor de cambio para el agro. En #JoyaDeLosSachas, el ministro @EizaguirreEc, visitó la Estación Experimental Central de la Amazonía de @INIAPECUADOR, donde evidenció el trabajo que realiza este instituto en varios cultivos de la zona.

Por el odio que destilan en redes, incluso nombrando a Dios, es que estamos, en parte, como estamos. Hicieron Presidente a alguien que se olvidó de gobernar para la gran mayoría y que no conserva ni la mínima de humanidad. No tenemos seguridad, pero tampoco educación, salud ni…
Fernando Villavicencio denunciaba a 10 personas diferentes por día, tenía miles de enemigos, ¿En serio van a creer que el partido que más chances de ganar tiene lo va a mandar a matar a 10 días de unas elecciones? Pedirles sentido común es demasiado
#LosRíos | Más de 30 estudiantes del @IST_TSA_CHILA conocieron el laboratorio de suelos y aguas de la Estación Exp. Tropical Pichilingue para aprender sobre el estado de fertilidad de los suelos y así proyectar el manejo de una fertilización balanceada de los diferentes cultivos.



La felicidad no depende de lo que nos pueda pasar sino de cómo percibimos aquello que nos ocurre
Guillermo Lasso habla de cientos de obras, de miles de millones de inversión, de un país seguro y un gobierno eficiente. Yo no consumo drogas, pero me gustaría probar lo que sea que se está metiendo Guillermo, para poder vivir en el mismo país que él.
Un individuo no puede alcanzar la grandeza si no está primero en la miseria, pará ser alguien tienes que saber lo que es ser nadie...
Hoy pido justicia ya que mataron a mi abogado que seguía mi caso por violacion de parte del Coronel activo de la policía DIEGO PAVON, y lo responsabilizó a él si algo le llega a pasar a mi hermana y a mi mamá que están en el país. Es un delicuente que se escuda con el uniforme.



Duele saber que hiciste lo mejor que pudiste y saber que todavía, no es lo suficientemente bueno.

United States Trends
- 1. #AEWGrandSlam N/A
- 2. #RivalsUniteInDokkan N/A
- 3. Tessa N/A
- 4. Flau’jae N/A
- 5. #NBAAllStar26 N/A
- 6. Texas Tech N/A
- 7. Janis Joplin N/A
- 8. #Svengoolie N/A
- 9. #OPLive N/A
- 10. Elvis Presley N/A
- 11. Arizona N/A
- 12. Keshad Johnson N/A
- 13. Joyce N/A
- 14. Jaxson Hayes N/A
- 15. South Carolina N/A
- 16. Austin Hill N/A
- 17. Marilyn Monroe N/A
- 18. Billy Richmond N/A
- 19. Mac McClung N/A
- 20. Raven Johnson N/A
Something went wrong.
Something went wrong.



















































































































